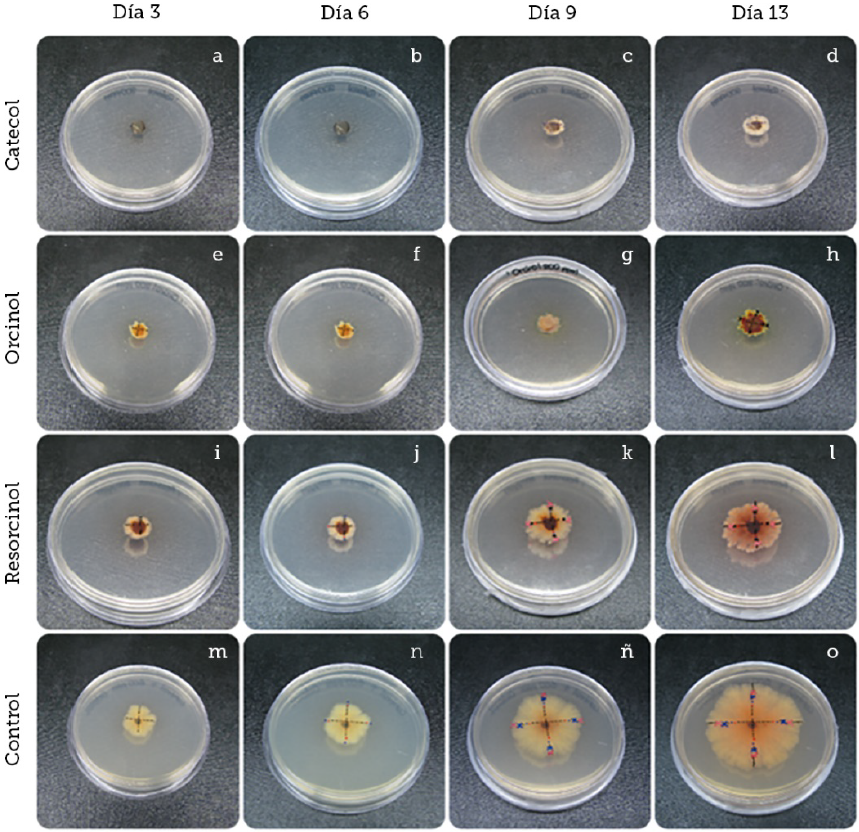

Introducción
Según datos de la Organización de las Naciones Unidas para la Alimentación y la Agricultura (FAO, por sus siglas en inglés), en el 2014 Oaxaca ocupó el quinto lugar estatal de producción de diferentes cultivos a nivel nacional; de los cuales la producción del fruto de papaya (Carica papaya L.) ocupó el primer lugar a nivel nacional (Servicio de Información Agroalimentaria y Pesquera [SIAP], 2014). Sin embargo, el cultivo es altamente susceptible al ataque de fitopatógenos que afectan al fruto principalmente en la etapa postcosecha (Casarrubias, Cárdenas, Nieto & Gutiérrez, 2002). Dentro de las enfermedades de mayor impacto en el cultivo de papaya, se destaca la antracnosis, causada por Colletotrichum spp., agente de tipo fúngico (Da Silva et al., 2007), siendo esta la principal enfermedad que afecta el cultivo (Luna, Gutiérrez, Baños, Colinas & Zavaleta, 2004). Sin embargo, Colletotrichum spp. afecta diversos frutos de importancia económica, el género presenta una alta variedad morfológica, genotípica y fitopatogénica (Casarrubias et al., 2003). En aguacate, por ejemplo, ocasiona pérdidas en postcosecha (Montero et al., 2010; Rodríguez, González & Mayek, 2009); el mango es susceptible de manera similar (Archana, Prabakar & Raguchander, 2014); además, afecta cultivos cafetaleros (Marulanda, Isaza, & Ramírez, 2007). En lulo, las pérdidas ocasionadas son considerables en su producción (Caicedo & Higuera, 2011); en tomate de árbol suelen ser predominantes las pérdidas (Martínez, Hío, Osorio & Torres, 2009); en cultivos de ñame ocasiona pérdidas considerables (Giraldo, Bustamante, Pinzón & Buitrago, 2016; Green, Abang & Iloba, 2000); y en guanábana causa daños casi totales (Álvarez, Ospina, Mejía & Llano 2004).
Según Dean, R., Van, J., Pretorius, A., Hammond, K., Di, P., Spanu, P., Rudd, J., Dickman, M., Kahmann, R., Ellis, J., & Foster, G. en 2012, las especies de Colletotrichum se han clasificado debido a su importancia científica y económica en el top 10 de los patógenos fúngicos, dentro de los cuales, este género ocupó el octavo lugar en la clasificación mundial de patógenos de plantas. La antracnosis, en consecuencia, genera pérdidas importantes; ya que ocasionan una reducción en la calidad y cantidad de los cultivos. Las pérdidas pueden llegar hasta el 100%, dependiendo de las condiciones climáticas en donde se desarrolle el patógeno, causando daño desde la formación de la planta, el desarrollo del fruto y hasta la postcosecha (Landero, Lara, Andrade, Aguilar & Aguado, 2016).
Las características morfológicas microscópicas del hongo presentan generalmente acérvulos; en las micro preparaciones se pueden observar setas o espinas negras en los bordes o entre el conidióforo. Los conidios son hialinos de color marrón con los extremos curvados o elipsoidales, con un ápice redondeado, una base estrecha y truncada, aseptada, más o menos fusiforme y cilíndrica. También pueden formar peritecios, estos pueden estar solos o agrupados, ser globosos conteniendo ascas con esporas, claviformes o cilíndricos con ascosporas cilíndricas o fusiformes (Ventura, Costa & Silva, 2004).
Adicionalmente, es muy frecuente encontrar otras especies de Colletotrichum spp. causando enfermedades en un mismo cultivo (Santamaría, Díaz, Gutiérrez, Santamaría & Larqué, 2011). Los principales signos de la antracnosis se observan como tejido necrótico hundido donde una masa conidial se origina en el tejido afectado por el patógeno (Peres, Kuramae, Dias & De Souza, 2002).
Las plantas, por su parte, y a diferencia de los animales superiores, no pueden cambiar de entorno en defensa de un agente patógeno y, por carecer de sistema inmunológico, se vieron obligadas a evolucionar presentando mecanismos alternos de defensa muy diversos para contrarrestar el ataque de agentes fitopatógenos y así poder defenderse por sí mismas (Verpoorte & Alferman, 2000).
Las defensas de las plantas pueden estar presentes en todo momento o ser producidas a partir del ataque por un agente patógeno (Grayer & Harborne, 1994). En el primer caso, por ejemplo, la producción de compuestos fenólicos como el catecol, presente durante todo el proceso de desarrollo de la cebolla morada en cantidades relativamente bajas, le confieren a la planta resistencia a la antracnosis (Montes, 2009). El catecol (1,2-dihidroxibenceno), al igual que el orcinol (5-Metilresorcinol) y resorcinol (1,3-dihidroxibenceno), son compuestos fenólicos simples propios de las plantas (Céspedes & Marín, 2007). Los compuestos fenólicos están ampliamente distribuidos y pertenecen a la clase de metabolitos secundarios de gran importancia en el sistema planta-suelo (Siqueira, Nair, Hammerschmidt, Safir & Putnam, 1991). Adicionalmente, se ha determinado que algunos compuestos fenólicos, como el catecol, no tienen influencia alguna en las características de suelo como pH, contenido de materia orgánica nitrógeno y fosfato (Mallik, 1997), lo cual podría sugerirlos como una alternativa antifúngica de origen vegetal. Investigaciones previas han demostrado que están involucrados en la inducción de un amplio espectro de compuestos antimicrobianos como defensa (Puupponen et al., 2001).
El presente trabajo se realizó con objetivo de identificar genotípica y fenotípicamente cepas de Colletotrichum gloeosporioides procedentes de aislados de cultivos de papaya de la costa de Oaxaca, usando iniciadores específicos y universales (CgInt-ITS4) previamente reportados, así como morfología microscópica y macroscópica colonial de los aislados fúngicos. Por otro lado, se determinó in vitro la actividad antifúngica del catecol, orcinol y resorcinol a diferentes concentraciones en una cepa caracterizada usando procesamiento digital de imágenes y análisis estadístico.
Materiales y Métodos
Los cultivos monospóricos de Colletotrichum spp. fueron proporcionados por la Universidad del Mar (UMAR), campus Puerto Escondido, de una micoteca obtenida previamente a partir del muestreo de las principales zonas productoras de papaya de la costa de Oaxaca.
Los extractos de los compuestos fenólicos fueron proporcionados por el Departamento de Farmacología de la Universidad de la Cañada (UNCA), el medio de cultivo utilizado para realizar la evaluación in vitro de la actividad antifúngica fue papa dextrosa agar (PDA) y en la obtención de micelio para la extracción de ácido desoxirribonucleico (DNA, por sus siglas en inglés) se usó caldo papa dextrosa (PDB). Para la identificación a nivel molecular se utilizaron iniciadores específicos y universales Cg Int: (5’-GGCCTCCCGCCTCCGGGCGG-3’) e ITS 4 (5’-TCCTCCGCTTATTGATATGC-3’), previamente reportados (Álvarez et al. 2004; Garrido, Carbú, Fernández, Vallejo & Cantoral, 2009; Mills, Sreenivasaprasad & Brown, 1992). La síntesis de los iniciadores se desarrolló en Oligo T4 y los experimentos se llevaron a cabo en el Laboratorio de Genética y en el de Microbiología de la Universidad del Mar, campus Puerto Escondido.
Reactivación y crecimiento de las cepas
La reactivación fúngica consistió en tomar un disco del micelio de un cultivo monospórico conservado en agua estéril a temperatura ambiente, inoculándolo en una caja Petri conteniendo PDA. Se observó el crecimiento radial característico del hongo sobre el medio de cultivo sólido y las cepas fueron analizadas y seleccionadas corroborando su morfología colonial, color y aspecto del micelio aéreo y vegetativo.
Preparación de frotis
Para corroborar que los cultivos pertenecieran al género de Colletotrichum spp. a partir de las cepas reactivadas, se realizaron frotis directos teñidos con azul de lactofenol, se observaron con un microscopio óptico con el objetivo de 10X y 40X, y se utilizaron claves de identificación taxonómica para la caracterización de los cultivos (Barnett & Hunter, 1998; Watanabe, 2000).
Extracción de DNA
Para la identificación molecular de las cepas Colletotrichum gloeosporioides, se cosechó micelio a partir de las cepas reactivadas en medio líquido acidificado con ácido láctico, con agitación constante a 100 revoluciones por minuto (rpm) y mantenidas a 27 °C. El micelio obtenido fue usado para realizar la extracción de DNA genómico de acuerdo al método reportado por Raeder & Broda en 1985. Para corroborar la integridad del DNA se realizó electroforesis horizontal en un gel de agarosa (Invitrogen) al 0.8% (p/v), cargando en el gel 2 microlitros (µL) del DNA genómico y 1 µL de solución de carga 6X (azul de bromofenol 0.25%, azul de xilencianol 0.25% y glicerol) en una cámara de electroforesis (Bio-Rad modelo: Mini-Sub® Cell GT) con solución de corrida TAE 1X (40 mM Tris-HCl, 20 mM ácido acético y 1 mM EDTA pH 8.0), usando una fuente de poder (Bio-Rad modelo: POWER PACTM HC) durante 45 min a 80 volts, 0.09 Amperes y 7 watts de potencia. Posteriormente, el gel fue teñido con una solución de bromuro de etidio (Sigma-Aldrich), visualizado en un transiluminador (Vilber Lourmat modelo: Quantum-1000/26M) y fotodocumentado; la calidad y cantidad del DNA se determinó en un espectrofotómetro (Thermo Scientific® modelo: Genesys 6) a una longitud de onda de 260 nanómetros (nm) y 280 nm.
Amplificación por PCR
El DNA genómico obtenido se utilizó como molde en la reacción en cadena de la polimerasa (PCR, por sus siglas en inglés). Se usaron iniciadores sintetizados por OligoT4 a una concentración de 50 nanomoles; el método de purificación fue estándar desalado. Para la amplificación se utilizó 2 µL de DNA genómico (20 ng/µL), 0.5 µL deoxinucleótidos trifosfato dNTPs a 10 mM (Sigma-Aldrich), 0.2 µL de Taq polimerasa a 5 U/µL (Biotecmol), 2.5 µL de amortiguador de PCR a 10X (Biotecmol), y 1.5 microlitros de cloruro de magnesio a 25 milimolar (Biotecmol) (Mills et al., 1992). La mezcla de reacción fue realizada en tubos de 0.2 mL a un volumen final de 25 µL, la reacción se llevó a cabo en un termociclador (Bio-Rad modelo PTC-100®). Las condiciones de amplificación consistieron en la desnaturalización a 95 °C por 2 min, y cada ciclo consistió en 30 s a 94 °C para desnaturalización, 30 s a 55 °C para alineamiento y 120 s a 72 °C de extensión, realizando un total de 40 ciclos; finalmente, una extensión de 4 min a 72 °C (Garrido et al., 2009). Los productos de amplificación fueron separados electroforéticamente en un gel de agarosa al 1.5% (p/v), a 60 volts durante 80 min.
Preparación de medio de cultivo suplementado
Para realizar los bioensayos se preparó PDA suplementado a tres diferentes concentraciones (200 ppm, 400 ppm y 600 ppm) de catecol, orcinol y resorcinol, dicho medio fue vertido en cajas Petri de 90 mm × 15 mm debidamente rotuladas con el compuesto y su concentración final.
Inoculación en medio suplementado con compuestos fenólicos
Con la ayuda de un sacabocado, previamente esterilizado, se procedió a extraer un disco de micelio de aproximadamente 0.5 mm2 de la cepa previamente identificada como Colletotrichum gloeosporioides. Se procedió a inocular con un disco a cada caja Petri con PDA suplementado con los diferentes compuestos fenólicos y por triplicado para cada compuesto y concentración, el disco del micelio fue colocado en la parte central de la caja Petri (previamente marcada). El control consistió en inocular un disco con el micelio de Colletotrichum gloeosporioides en medio PDA en ausencia de cualquier compuesto fenólico; finalmente, se incubaron las cajas a una temperatura de 27 °C, se monitoreó y midió diariamente el crecimiento radial de los cultivos.
Análisis con ImageJ®
Para evaluar el efecto en el crecimiento del hongo sobre placas de PDA suplementados con los diferentes ingredientes activos de la cepa de Colletotrichum gloeosporioides, se empleó el procesamiento de imágenes en los bioensayos, con el objetivo de determinar el área en milímetros cuadrados del crecimiento de la cepa, usando el software ImageJ® V.1.51 (Rasband, 2016). El análisis consistió en cargar la imagen en el programa y calibrarlo con el uso de la barra de herramientas, la calibración se realizó tomando como patrón de medida el diámetro de la caja de Petri que fue de 90 mm. Una vez calibrado, se procedió a utilizar la herramienta de polígono para delimitar las zonas de crecimiento micelial; adicionalmente, se llevó a cabo el proceso de medición con el uso del icono Analyse/measure situado en la barra de herramientas del programa donde se obtuvo el valor del área seleccionada en mm2 indicando el crecimiento del micelio en la placa.
Diseño experimental y análisis estadístico
Para determinar el efecto de inhibición de crecimiento radial de Colletotrichum gloeosporioides, expresado en mm2 de dichos compuestos fenólicos, se realizó un diseño factorial teniendo como fuentes de variación a los ingredientes activos, la concentración y tiempo de medición. El procesamiento estadístico de la información se realizó con un análisis de varianza y comparación de medias a través de la prueba de Tukey (p < 0.05) usando el software de Análisis Estadístico SAS V9.0® (SAS, 2003).
Resultados y Discusión
Caracterización morfológica
La morfología colonial de las cepas reactivadas del género Colletotrichum spp. fue muy diversa, incluyendo la coloración del anverso y reverso de la placa, lo cual se puede observar en la Figura 1 (a, b y c), en donde se observan los patrones de crecimiento del hongo que se ha desarrollado sobre PDA a 27 °C. En algunas placas, la atenuación en el color de la colonia cambió con la edad del cultivo, y las variaciones en la morfología colonial se observaron a lo largo del desarrollo de las cepas sobre agar papa dextrosa y con la temperatura de incubación, resaltando el crecimiento radial de Colletotrichum gloeosporioides en algunas de ellas, en cuyo micelio se observaron márgenes enteros y ondulados en algunos casos. En el crecimiento aéreo exhibió un color blanco y gris o naranja; adicionalmente, en algunas cepas se observó una ligera pigmentación naranja solo en el centro del cultivo, como se muestra en la Figura 1c.

Fuente: Elaboración propia.
Figura 1 Patrones de crecimiento sobre agar papa dextrosa de las diversas cepas de Colletotrichum spp. (a, b y c). Morfología microscópica de las conidias de Colletotrichum spp. (d, e y f) teñidas con azul de lactofenol y observadas en un microscopio óptico con objetivo 40X. Morfología del cultivo de Colletotrichum gloeosporioides en PDA y morfología de las conidias observadas en microscopio óptico con el objetivo de 40X tenidas con azul de lactofenol (c y f).
Las micro preparaciones con azul de lactofenol permitieron la complementación de la identificación de Colletotrichum gloeosporioides. Las micrografías de los conidios del género fueron representativas, mismas que incluyen morfología cilíndrica con bordes redondeados (Figura 1 [d, e y f]), sin embargo, la identificación incluso comparando las características morfológicas macroscópicas y microscópicas no es determinante a este nivel, debido a la amplia variación de morfología que exhibe el hongo a diferentes temperaturas de crecimiento y el sustrato usado para su desarrollo.
Caracterización Molecular
Se seleccionaron tres cepas distintivas morfológicamente pertenecientes al género Colletotrichum, presuntivamente la especie C. gloeosporioides, y se obtuvo el DNA usando el protocolo para hongos filamentosos. El DNA cuantificado con espectrofotometría, y corroborada su integridad electroforéticamente, se empleó como molde en la PCR. Los resultados de la amplificación usando los cebadores seleccionados y de acuerdo a la metodología descrita, para la identificación de Colletotrichum gloeosporioides, fueron positivos. El producto de amplificación consistió en un fragmento de 450 pb (Mills et al., 1992). En la Figura 2 se muestran los resultados de la amplificación, los amplicones fueron separados electroforéticamente en un gel horizontal de agarosa al 1.5%, teñidos con bromuro de etidio, observado con una lámpara de luz ultravioleta y fotodocumentado. Los resultados moleculares permitieron la corroboración de la identificación de Colletotrichum gloeosporioides, según lo reportado por otros investigadores.

Fuente: Elaboración propia.
Figura 2 Electroforesis en gel de agarosa al 1.5% de los productos de PCR (Carril MW). marcador de tamaño molecular 1 kb DNA Ladder (Pomega). Carriles (1-3) Amplificación de fragmentos de cepas de Colletotrichum gloeosporioides. Carril 4. Control negativo, se utilizó como molde DNA de Fusarium sp para la amplificación.
Pruebas in vitro de crecimiento micelial
Los resultados que se muestran en el presente estudio nos permitieron demostrar que Colletotrichum gloeosporioides presentó sensibilidad a los tres compuestos fenólicos en diferente grado y de acuerdo a las mediciones realizadas del crecimiento radial de las cepas del fitopatógeno., con el uso de imageJ® y el análisis de varianza general, que incluyó todas las observaciones realizadas en dicho trabajo, los diferentes compuestos fenólicos, así como sus diversas concentraciones utilizadas, inhibieron de manera parcial y total el desarrollo filamentoso del hongo.
En la Tabla 1, de manera general, se puede observar que en el análisis de varianza de los tres compuestos fenólicos a una concentración de 200 ppm, los valores de varianza son estadísticamente diferentes en la mayoría de los casos, siendo que en la última observación las varianzas son similares en el caso de catecol y orcinol. Esto se puede comprobar en la Figura 3, donde se pudo determinar que Colletotrichum gloeosporioides presenta sensibilidad a los tres compuestos fenólicos de manera diferente. Por tanto, el orden de inhibición que presentaron los tres compuestos fenólicos se atribuyó en primer lugar al catecol que presentó un mayor grado de inhibición, seguido de orcinol y finalmente resorcinol, ya que en la concentración de 200 ppm se udo observar un moderado crecimiento con el compuesto resorcinol suplementado en los cultivo
Tabla 1 Análisis de varianza de los tratamientos a diferentes concentraciones expresados en partes por millón (ppm), número de observaciones e ingredientes activos (I.A) simbolizados (R: resorcinol, O: orcinol, C: catecol y C+ control.
| I.A | [C] | Obs. 1 | Obs. 2 | Obs. 3 | Obs. 4 | Obs. 5 | Obs. 6 | Obs. 7 |
|---|---|---|---|---|---|---|---|---|
| 200 ppm | f 0.0±0.0 | e 93.19±1.90 b | e 107.40±4.69 b | d 141.89±4.11 b | c 427.16±4.65 b | b 661.58±2.88 b | a 683.80±6.77 b | |
| R | 400 ppm | e 0.0±0.0 | d 24.86±0.69 c | c 32.96±1.02 c | c 35.87±0.83 c | b 56.26±1.03 c | a 96.58±1.05 c | a 98.24±0.44 c |
| 600 ppm | f 0.0±0.0 | e 0.20±0.02 d | e 0.26±0.01 d | c 0.32±0.02 d | c 0.39±0.02 c | a 0.44±0.02 d | a 0.49±0.03 c | |
| C+ | 0.0 ppm | g 0.0±0.0 | f 374.22±4.5 a | e 529.56±1.71 a | d 841.91±3.30 a | c 1553.33±33.56 a | b 2826.54±36.62 a | a 4329.24±59.20 a |
| 200 ppm | f 0.0±0.0 | e 27.90±0.57 b | e 41.90±1.05 b | d 59.72±1.92 b | c 85.72±1.32 b | b 129.39±2.50 b | a 165.42±8.79 b | |
| O | 400 ppm | e 0.0±0.0 | d 0.14±0.02 c | cd 0.16±0.02 c | bcd 0.19±0.02 c | abc 0.24±0.01 c | ab 0.26±0.02 c | a 0.28±0.02 c |
| 600 ppm | e 0.0±0.0 | d 0.06±0.01 c | cd 0.10±0.03 c | bc 0.11±0.01 c | ab 0.15±0.01 c | a 0.17±0.01 c | a 0.18±0.02 c | |
| C+ | 0.0 ppm | g 0.0±0.0 | f 374.22±4.5 a | e 529.56±1.71 a | d 841.91±3.30 a | c 1553.33±33.56 a | b 2826.54±36.62 a | a 4329.24±59.20 a |
| 200 ppm | g 0.0±0.0 | f 6.85±0.301 b | e 13.18±0.41 b | d 16.31±0.40 b | c 36.979±0.01 b | b 42.12±0.60 b | a 144.77±0.9 b | |
| C | 400 ppm | c 0.0±0.0 | bc 0.04±0.2 b | abc 0.09±0.04 c | ab 0.13±0.03 c | ab 0.1533±0.03 b | a 0.17±0.02 b | a 0.18±0.0 c |
| 600 ppm | d 0.0±0.0 | c 0.07±0.01 b | bc 0.09±0.01 c | bc 0.10±0.01 c | ab 0.1220±0.01 b | a 0.14±0.06 b | a 0.15±0.01 c | |
| C+ | 0.0 ppm | g 0.0±0.0 | f 374.22±4.50 a | e 529.56±1.71 a | d 841.91±3.30 a | c 1553.33±33.56 a | b 2826.54±36.62 a | a 4329.24±59.20 a |
a ,b,c,d .- Medias con diferente literal en la misma columna (mismo día e ingrediente activo) son estadísticamente diferentes (p < 0.05).
a,b,c,d,e,f,g .- Medias con diferente literales en la misma hilera (mismo producto y misma concentración) son estadísticamente diferentes (p < 0.05).
Los datos mostrados corresponden a las áreas de crecimiento del micelio; se encuentran en mm2 y representan la media de todas las observaciones.
Fuente: Elaboración propia.
Fuente: Elaboración propia.
Figura 3 Pruebas de inhibición de crecimiento de Colletotrichum gloeosporioides con los diferentes compuestos fenólicos a 200 ppm junto al control de crecimiento durante catorce días. Observaciones cualitativas realizadas del crecimiento radial a una concentración de 200 ppm de catecol (A-D). Observaciones realizadas de crecimiento radial a una concentración de 200 ppm de orcinol (E-H). Observaciones realizadas de crecimiento radial a una concentración de 200 ppm de resorcinol (I-L). Observaciones realizadas de crecimiento radial sin compuesto fenólico (M-O) .
Por otra parte, en el análisis de varianza se muestra que los tres compuestos fenólicos a una concentración de 400 ppm y 600 ppm, respectivamente, los valores de varianza son estadísticamente iguales en todas las observaciones, lo que probablemente significa que a dicha concentración tanto el catecol como el orcinol inhiben por completo el crecimiento radial de Colletotrichum gloeosporioides. En cuanto al resorcinol se pudo observar un mínimo crecimiento micelial. Esto se puede comprobar visualmente en la Figura 4 donde se pudo constatar que Colletotrichum gloeosporioides presenta sensibilidad a los tres compuestos fenólicos de manera diferente.

Fuente: Elaboración propia.
Figura 4 Pruebas de inhibición de crecimiento de Colletotrichum gloeosporioides, con los diferentes compuestos fenólicos a 400 ppm junto al control de crecimiento durante catorce días. (A-D) Observaciones cualitativas realizadas del crecimiento radial a una concentración de 400 ppm de catecol. (E-H) Observaciones realizadas de crecimiento radial a una concentración de 400 ppm de orcinol. (I-L) Observaciones realizadas de crecimiento radial a una concentración de 400 ppm de resorcinol. (M-O) observaciones realizadas de crecimiento radial sin compuesto fenólico.
Presentando de manera reproducible el siguiente orden de inhibición, catecol presentó mayor grado de inhibición, seguido de orcinol y por último resorcinol, aunque, en la concentración de 400 ppm se pudo observar un ligero crecimiento con el compuesto resorcinol. Sin embargo, se puede observar en la Figura 5 que Colletotrichum gloeosporioides presentó sensibilidad a los tres compuestos fenólicos de manera similar y que en la concentración de 600 ppm el resorcinol inhibió por completo el crecimiento micelial.

Fuente: Elaboración propia.
Figura 5 Pruebas de inhibición de crecimiento de Colletotrichum gloeosporioides con los diferentes compuestos fenólicos a 600 ppm junto al control de crecimiento durante catorce días. Observaciones cualitativas realizadas del crecimiento radial a una concentración de 600 ppm de catecol (A-D). Observaciones realizadas de crecimiento radial a una concentración de 600 ppm de orcinol (E-H). Observaciones realizadas de crecimiento radial a una concentración de 600 ppm de resorcinol (I-L). Observaciones realizadas de crecimiento radial sin compuesto fenólico (M-O).
De esta manera, los resultados indican que los tres compuestos fenólicos empleados inhiben en diferente grado el crecimiento del patógeno cosmopolita Colletotrichum gloeosporioides, que provoca la enfermedad conocida como antracnosis en una amplia variedad de frutos.
Dado que los catecoles pueden actuar como pro-oxidantes, dañando moléculas como el DNA y proteínas, estos pueden destruir la funcionalidad de la membrana debido a su actividad cíclica redox y, por otro lado, varias enzimas vegetales, animales y bacterias son capaces de catalizar la oxidación de catecol a benzoquinona, tal como la lacasa fúngica conteniendo cobre (Schweigert, Zehnder & Eggen, 2001).
Por otra parte, cuando el catecol es oxidado enzimáticamente o en la presencia de oxígeno y metales pesados, un electrón es transferido al oxígeno molecular, por lo que se forma de esta manera el radical superóxido (O2-). En la presencia de metales pesados, como el hierro y cobre, el radical superóxido es convertido a peróxido de hidrógeno (H2O2) y radicales hidróxilo (∙OH); estas especies de oxígeno reactivo pueden ser dañinas a las células y organismos si no son debidamente eliminados por enzimas especializadas en dicha degradación, como las peroxidasas, lo cual sugeriría que el catecol afecta significativamente en el crecimiento micelial de Colletotrichum gloeosporioides en concentraciones muy bajas (200 ppm), como las mostradas en la presente investigación. El grado de inhibición por parte del orcinol se ubicó en un término medio de las concentraciones aquí empleadas, siendo efectivo a 400 ppm; sin embargo, el resorcinol por otra parte requirió una concentración mayor para la inhibición total del desarrollo del fitopatógeno (600 ppm), como se observa en la Figura 5.
Conclusiones
Los estudios relacionados con la caracterización de cepas del género Colletotrichum se han basado actualmente en estudios moleculares con ITS, dada la complejidad que implica la identificación de cepas que exhiben amplias variaciones macroscópicas y microscópicas, sin embargo, no se excluyen en ninguno de ellos los análisis morfológicos coloniales integrando las claves taxonómicas del fitopatógeno.
Por otro lado, los compuestos fenólicos catecol, orcinol y resorsinol inhibieron in vitro a diferentes concentraciones el crecimiento total de Colletrotrichum gloeosporioides, no obstante, es necesario complementar los estudios aquí mostrados con pruebas in vivo, en interacción planta-patógeno con el objetivo de demostrar el papel de estos compuestos sobre crecimiento, diferenciación o patogénesis, y tentativamente proponerlos como agentes de protección durante el periodo de postcosecha, etapa donde el patógeno es más común y severo.











 nova página do texto(beta)
nova página do texto(beta)


